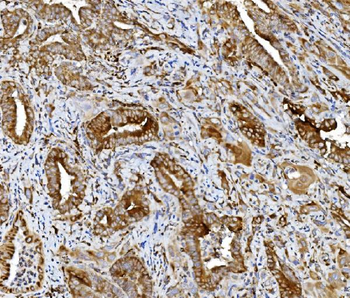
PDIA5 Rabbit Polyclonal Antibody

You have no items in your shopping cart.
- MVP Mouse Monoclonal Antibody [orb610911]
FC, ICC, IF, IHC, WB
Human, Mouse, Rat
Mouse
Monoclonal
Unconjugated
100 μg - PDIA5 Rabbit Polyclonal Antibody [orb745917]
ELISA, FC, ICC, IF, IHC, WB
Human, Mouse, Rat
Rabbit
Polyclonal
Unconjugated
100 μg - HNRNPH3 Rabbit Polyclonal Antibody [orb738448]
ELISA, FC, ICC, IF, IHC, WB
Human
Rabbit
Polyclonal
Unconjugated
100 μg - PRDM14 Rabbit Polyclonal Antibody [orb745923]
FC, ICC, IF, IHC, WB
Human, Mouse, Rat
Rabbit
Polyclonal
Unconjugated
100 μg - KHSRP Rabbit Polyclonal Antibody [orb763126]
ELISA, FC, ICC, IF, IHC, IP, WB
Human, Rat
Rabbit
Polyclonal
Unconjugated
100 μg - Ku70 Mouse Monoclonal Antibody [orb738486]
FC, ICC, IF, IHC, WB
Human
Mouse
Monoclonal
Unconjugated
100 μg - CD34 Rabbit Polyclonal Antibody [orb738369]
ELISA, IF, IHC, WB
Human, Rat
Rabbit
Polyclonal
Unconjugated
100 μg - Histone H1.0/H1F0/H1 Mouse Monoclonal Antibody [orb1145786]
FC, IHC, WB
Human, Mouse
Mouse
Monoclonal
Unconjugated
100 μg - ENO1 Rabbit Polyclonal Antibody [orb1145817]
ELISA, FC, IHC, WB
Human
Rabbit
Polyclonal
Unconjugated
100 μg - AHA1/AHSA1 Rabbit Polyclonal Antibody [orb1145840]
ELISA, FC, ICC, IF, IHC, WB
Human, Mouse, Rat
Rabbit
Polyclonal
Unconjugated
100 μg